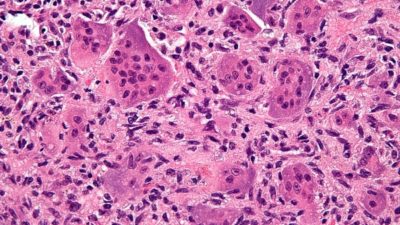

| Course Credits | | 3 (3-0-6) |
| Course Abbrviation | | GEN BIO I |
| Course Title (TH) | | ชีววิทยาทั่วไป 1 |
| Course Title (EN) | | GENERAL BIOLOGY I |
| Responsible Unit | | Faculty of Science, Department of Biology |
| Type of Course | | International Course |
| Semester | | Intl 1st semester |
| Academic Year | | 2024 |
| Course Coordinator | | |
| Measurement Method | | |
| Type of Course | | Semester Course |
| Course Condition | | None |
| Course Status | | Required Course |
| Instructors / staffs | | |
| Enrollment conditions | | None |
| Degree level | | Bachelor |
| Related curricular | | Bachelor of Science in Biotechnology (2562) |
| | Bachelor of Science in Biotechnology (2567) |
| Course description (TH) | | แนะนําเบื้องต้นเกี่ยวกับเรื่องของเซลล์ซึ่งเป็นหน่วยพื้นฐานของสิ่งมีชีวิต แนวคิดสมัยใหม่ในเรื่องของเซลล์ การจัดระเบียบ โครงสร้าง และหน้าที่ของเซลล์ สรีรวิทยาเปรียบเทียบในสัตว์ชนิดต่าง ๆ การสืบพันธุ์ การเจริญ วิวัฒนาการ นิเวศวิทยา พฤติกรรมของสัตว์ และความหลากหลายทางชีวภาพ |
| Course description (EN) | | An Introduction to the cell as the basic unit of life; modern cell concepts; cell organization; cell structure and function; comparative approach of animal physiology; reproduction; development; evolution; ecology; animal behavior and biodiversity. |
| Curriculum mapping | / | CU-1.1: Behavioral Objectives Possessing well-rounded knowledge |
| / | CU-1.2: Possessing in-depth knowledge |
| | CU-2.1: Being moral and ethical |
| | CU-2.2: Having an awareness of etiquette |
| / | CU-3.1: Being able to think critically |
| / | CU-3.2: Being able to think creatively |
| / | CU-3.3: Having skills in problem solving |
| | CU-4.1: Having professional skills |
| | CU-4.2: Having communication skills |
| | CU-4.3: Having skills in information technology |
| | CU-4.4: Having mathematical and statistical skills |
| | CU-4.5: Having management skills |
| | CU-5.1: Having an inquiring mind |
| | CU-5.2: Knowing how to learn |
| | CU-5.3: Having leadership qualities |
| | CU-5.4: Maintaining well-being |
| | CU-5.5: Being community-minded and possessing social responsibility |
| | CU-5.6: Sustaining Thainess in a globalized world |
| / | subPLO1.1 Explain biotechnology knowledge in practice. |
| | subPLO1.2 Analyze biotechnology knowledge in practice. |
| | subPLO1.3 Apply biotechnology knowledge in practice. |
| / | PLO2 Employ biotechnology-related technology and scientific tools. |
| | PLO3 Communicate effectively in English within the Biotechnology field. |
| | PLO4 Demonstrate behavior that aligns with ethical principles, moral values, and professional ethics. |
| | PLO5 Demonstrate social responsibility, courage, and creativity. |
| Course learning outcome (CLO) | | 1. Explain biological principles from cells to ecosystems. |
| | 2. Explain and give examples of biological applications in daily life. |